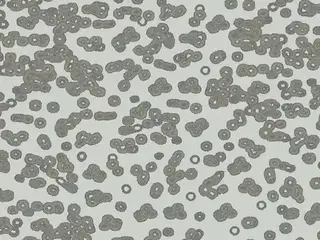
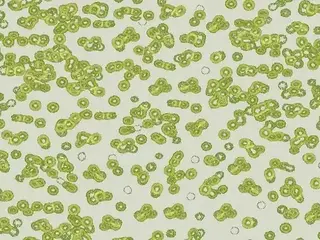

Лакокрасочные материалы
- Краски
- Эмали
- Разметочные
- Спреи
- Добавки для красок
- Лаки
- Для напольных покрытий
- Лазури
- Добавки для лаков
- Пропитки
- Гидрофобизаторы
- Олифа
- Отбеливатели
- Масло
- Воск
- Морилки
- Антисептики
- Грунтовки
- Декоративные покрытия
- Растворители
- Уайт-спирит
- Ацетон
- Керосин
- Ксилол
- Бензин
- Скипидар
- Толуол
- Нефрас
- Сольвент
- Очистители
- Герметика
- Для удаления обоев
- Клея
- Ржавчины
- Пены
- Смывки
- Разбавители
- Смазки
- Колеры, тонеры, красители
- Материалы для покраски
- Кисти
- Валики
- Ванночки для краски
- Губки
- Ленты малярные
- Миксеры
- Наборы малярные
- Отвердители
- Пистолеты-распылители
- Удлинители малярные
- Защита рук и органов дыхания
- Маски защитные
- Перчатки
- Противогазы
- Респираторы
- Рукавицы
Клей, герметики, пена
- Клей
- Канцелярский
- Обойный
- Плиточный
- Для напольных покрытий
- Автомобильный
- Сухие (смеси)
- Жидкие гвозди
- Холодная сварка
- Химические анкеры
- Жидкое стекло
- Добавки для клея
- Герметики
- Автомобильные
- Для напольных покрытий
- Мастики
- Жидкая резина
- Монтажная пена
- Очистители
- Герметиков
- Клея
- Пены
- Пистолеты
- Для герметиков аккумуляторные
- Для герметиков ручные
- Для монтажной пены
- Клеевые
- Распылители
Отделочные материалы
Напольные покрытия
Обои
Плитка
Сыпучие смеси
- Для стен
- Шпатлевки
- Штукатурки
- Декоративные покрытия
- Жидкие обои
- Для пола
- Полы наливные
- Ровнители
- Стяжки
- Для плитки
- Клей
- Затирки
- Смеси кладочные
- Смеси клеевые
- Смеси ремонтные
- Общестроительные материалы
- Алебастр
- Гипс
- Известь
- Мел
- Пескобетон
- Побелка
- Цемент
Изоляция
- Битумная изоляция
- Гидроизол
- Гидростеклоизол
- Пергамин
- Рубемаст
- Рубероид
- Стеклоизол
- Каучуковая изоляция
- Полимерная изоляция
- Мембраны
- Пенопласт
- Пенополистирол
- Пенополиуретан
- Пенополиэтилен
- Ленты уплотнительные (ПСУЛ)
- Ленты строительные
- Геотекстиль
- Минеральная вата
- По области применения
- Теплоизоляция
- Гидроизоляция
- Пароизоляция
- Ветроизоляция
- Звукоизоляция
- Огнезащита
- Герметики
- Жидкая резина
- Жидкие гвозди
- Жидкое стекло
- Мастики
- Монтажная пена
Листовые материалы
- Гипсокартон
- ГКЛ
- ГКЛВ
- ГКЛВО
- ГКЛО
- ГВЛВ
- ГВЛ
- Профили ГКЛ
- Крепления ГКЛ
- Гипсоплиты
- Стеклосетки
- Серпянки
- Пленки укрывные
- Ленты
- Малярные
- Алюминиевые
- Армированные
- Армирующие
- Сигнальные
- Скотчи
- Изоленты
- Уплотнительные
- Монтаж плитки и гипсокартона
- Зажимы
- Крестики
- Клинья
- Клей плиточный
- Ножовки
- Рубанки
- Шуруповерты
Инструменты
Электроинструменты
Ручные инструменты
Садовые инструменты
Высотное оборудование
- Сверлильные
- Винтоверты
- Гайковерты
- Дрели
- Дрели алмазного сверления
- Дрели-шуруповерты
- Миксеры
- Насадки для миксеров
- Молотки отбойные
- Отвертки аккумуляторные
- Перфораторы
- Шуруповерты
- Пильно-отрезные
- Болгарки
- Лобзики
- Реноваторы
- Пилы алмазные
- Пилы дисковые
- Пилы монтажные
- Пилы сабельные
- Пилы торцовочные
- Пилы циркулярные
- Станки фрезерные
- Фрезеры
- Штроборезы
- Электроножовки
- Электрорубанки
- Для обработки поверхностей
- Станки точильные
- Шлифмашины вибрационные
- Шлифмашины ленточные
- Шлифмашины по бетону
- Шлифмашины полировальные
- Шлифмашины прямошлифовальные
- Шлифмашины щеточные
- Шлифмашины эксцентриковые
- Садовая техника
- Газонокосилки аккумуляторные
- Газонокосилки бензиновые
- Газонокосилки электрические
- Культиваторы аккумуляторные
- Культиваторы бензиновые
- Культиваторы электрические
- Кусторезы аккумуляторные
- Кусторезы бензиновые
- Кусторезы электрические
- Ножницы аккумуляторные
- Мотоблоки
- Мотобуры
- Пилы цепные аккумуляторные
- Пилы цепные бензиновые
- Пилы цепные электрические
- Триммеры аккумуляторные
- Триммеры бензиновые
- Триммеры электрические
- Садовые пылесосы аккумуляторные
- Садовые пылесосы бензиновые
- Садовые пылесосы электрические
- Воздуходувки аккумуляторные
- Воздуходувки бензиновые
- Воздуходувки электрические
- Измельчители бензиновые
- Измельчители электрические
- Пистолеты
- Краскопульты
- Клеевые
- Термопистолеты
- Фены строительные
- Прочие инструменты
- Сварочные аппараты
- Генераторы
- Компрессоры
- Наборы инструментов
- Комплектующие
- Для плиткорезов
- Для сварочных аппаратов
- Защита рук и глаз
- Очки защитные
- Краги
- Перчатки
- Рукавицы
Автохимия
- Для малярных работ
- Грунтовки
- Лаки
- Пропитки
- Эмали
- Шпатлевки
- Отвердители
- Добавки
- Очистители
- Растворители
- Разбавители
- Уход за кузовом и салоном
- Ароматизаторы салона
- Воски
- Полироли
- Шампуни
- Технические жидкости
- Антифриз
- Масла
- Присадки
- Смазки
- Герметики
- Клей
- Губки
- Салфетки
- Щетки
- Наборы авто инструментов
Отопление
- Водонагреватели
- Накопительные
- Проточные
- Косвенного нагрева
- Бойлеры
- Котлы
- Газовые
- Конденсационные
- Электрические
- Электрические тэновые
- Завесы тепловые
- Теплогенераторы
Спецодежда и СИЗ
Бытовые товары
- Для стирки
- Стиральный порошок
- Гели и жидкости
- Капсулы, таблетки, пластины
- Отбеливатели и пятновыводители
- Кондиционеры и ополаскиватели
- Для глаженья
- Для посуды
- Губки
- Средства для мытья посуды
- Средства для посудомоечных машин
- Чистящие и моющие
- Антиплесень
- Для кафеля, сантехники и труб
- Для кухни
- Для мебели
- Для пола и напольных покрытий
- Для стекол и зеркал
- Для бытовой техники
- Для посудомоечных машин
- Для стиральных машин
- Для кухонной техники
- Для утюгов
- Для компьютерной техники
- Для кондиционеров
- Специальные
- Универсальные
- Салфетки и тряпки бытовые
- Салфетки бытовые
- Тряпки бытовые
- Бумажные полотенца
- Бытовые
- Листовые
- Профессиональные
- Рулонные
- Туалетная бумага
- Бытовая
- Влажная
- Листовая
- Профессиональная
- Рулонная
- Прочие бумажные и ватные изделия
- Платочки бумажные
- Покрытия одноразовые для унитаза
- Салфетки антибактериальные
- Салфетки бумажные
- Салфетки влажные
- Диспенсеры
- Для полотенец
- Для туалетной бумаги
- Для салфеток
- Мыло туалетное
- Жидкое
- Крем-мыло
- Детское
- Хозяйственное
- Дозаторы для жидкого мыла
- Освежители воздуха
- Диспенсеры
- Диффузоры аромамасел
- Диффузоры ароматические
- Свечи ароматизированные
- От насекомых и грызунов
- От грызунов
- От клещей
- От клопов
- От комаров
- От моли
- От мошек
- От муравьев
- От мух
- От тараканов
- Мешки для мусора
 Forbo
Forbo  Клей Forbo
Клей Forbo  Клей для напольных покрытий Forbo
Клей для напольных покрытий Forbo  Покрытия напольные
Покрытия напольные  Смеси сухие Forbo
Смеси сухие Forbo  Герметики Forbo
Герметики Forbo  Грунтовки Forbo
Грунтовки Forbo  Расходные материалы Forbo
Расходные материалы Forbo  Ленты строительные Forbo
Ленты строительные Forbo  Смеси ремонтные Forbo
Смеси ремонтные Forbo  Мастики Forbo
Мастики Forbo  Бытовая химия Forbo
Бытовая химия Forbo  Средства универсальные Forbo
Средства универсальные Forbo  Средства для пола и напольных покрытий Forbo
Средства для пола и напольных покрытий Forbo  Средства чистящие и моющие Forbo
Средства чистящие и моющие Forbo  Ровнители Forbo
Ровнители Forbo  Смеси для пола Forbo
Смеси для пола Forbo  Ковролин
Ковролин  Ковролин коммерческий
Ковролин коммерческий  Покрытия напольные Forbo
Покрытия напольные Forbo  Линолеум Forbo
Линолеум Forbo  Линолеум гетерогенный Forbo
Линолеум гетерогенный Forbo  Линолеум коммерческий Forbo
Линолеум коммерческий Forbo  Ковролин бытовой
Ковролин бытовой  Forbo Flotex Sottsass флокированное ковровое покрытие
Forbo Flotex Sottsass флокированное ковровое покрытие
Forbo Flotex Sottsass флокированное ковровое покрытие
Товары
Фотографии
124 тыс. наименований товаров от 2682 брендов в 686 категориях
Информация не является публичной офертой
Политика конфиденциальности © 2007–2024 Бафус ООО